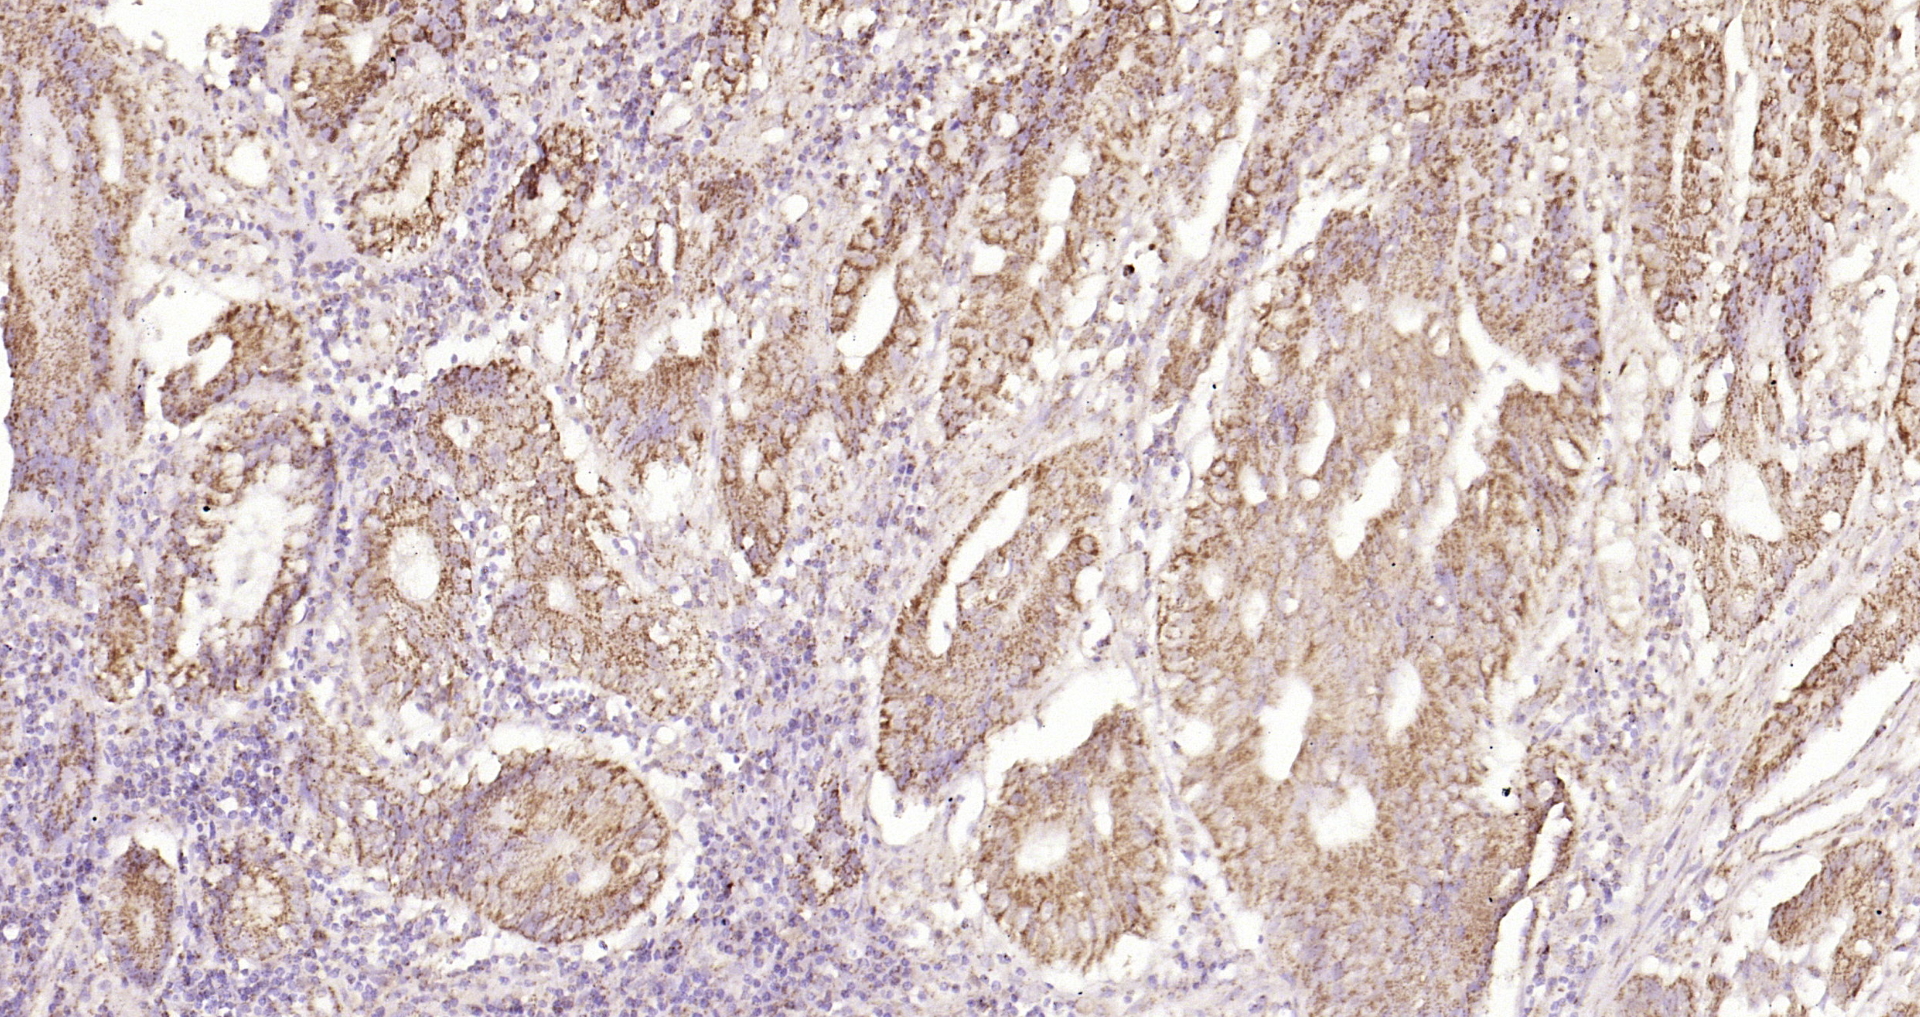
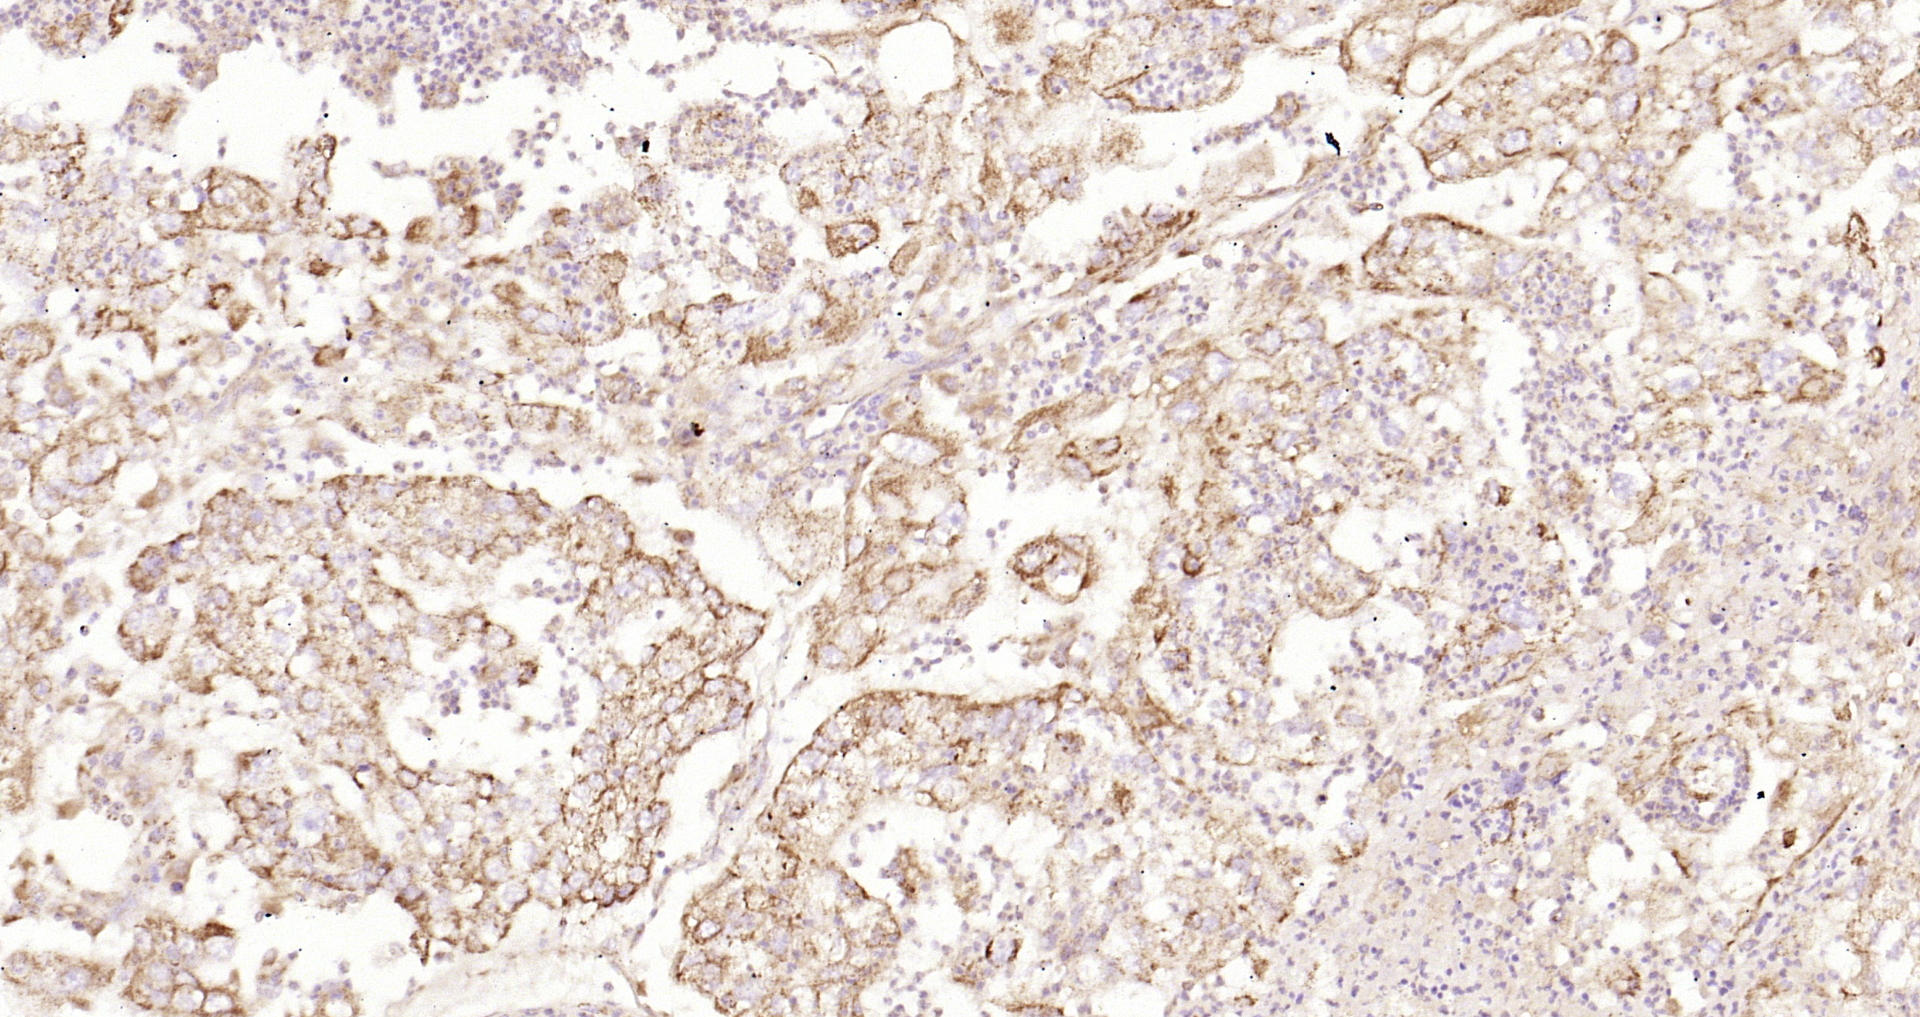
Paraformaldehyde-fixed, paraffin embedded Human endometrial carcinoma; Antigen retrieval by boiling in sodium citrate buffer (pH6.0) for 15min; Block endogenous peroxidase by 3% hydrogen peroxide for 20 minutes; Blocking buffer (normal goat serum) at 37°C for 30min; Antibody incubation with Ecat1 Polyclonal Antibody, Unconjugated (bs-13596R) at 1:200 overnight at 4°C, DAB staining.

Paraformaldehyde-fixed, paraffin embedded Human colon cancer; Antigen retrieval by boiling in sodium citrate buffer (pH6.0) for 15min; Block endogenous peroxidase by 3% hydrogen peroxide for 20 minutes; Blocking buffer (normal goat serum) at 37°C for 30min; Antibody incubation with Ecat1 Polyclonal Antibody, Unconjugated (bs-13596R) at 1:200 overnight at 4°C, DAB staining.
Ecat1 Polyclonal Antibody
BS-13596R
ApplicationsImmunoFluorescence, ELISA, ImmunoCytoChemistry, ImmunoHistoChemistry, ImmunoHistoChemistry Frozen, ImmunoHistoChemistry Paraffin
Product group Antibodies
ReactivityHuman
Overview
- SupplierBioss
- Product NameEcat1 Polyclonal Antibody
- Delivery Days Customer16
- ApplicationsImmunoFluorescence, ELISA, ImmunoCytoChemistry, ImmunoHistoChemistry, ImmunoHistoChemistry Frozen, ImmunoHistoChemistry Paraffin
- Applications SupplierELISA(1:500-1000), IHC-P(1:200-400), IHC-F(1:100-500), IF(IHC-P)(1:50-200), IF(IHC-F)(1:50-200), IF(ICC)(1:50-200)
- CertificationResearch Use Only
- ClonalityPolyclonal
- Concentration1 ug/ul
- ConjugateUnconjugated
- HostRabbit
- IsotypeIgG
- ReactivityHuman
- Storage Instruction-20°C
- UNSPSC41116161